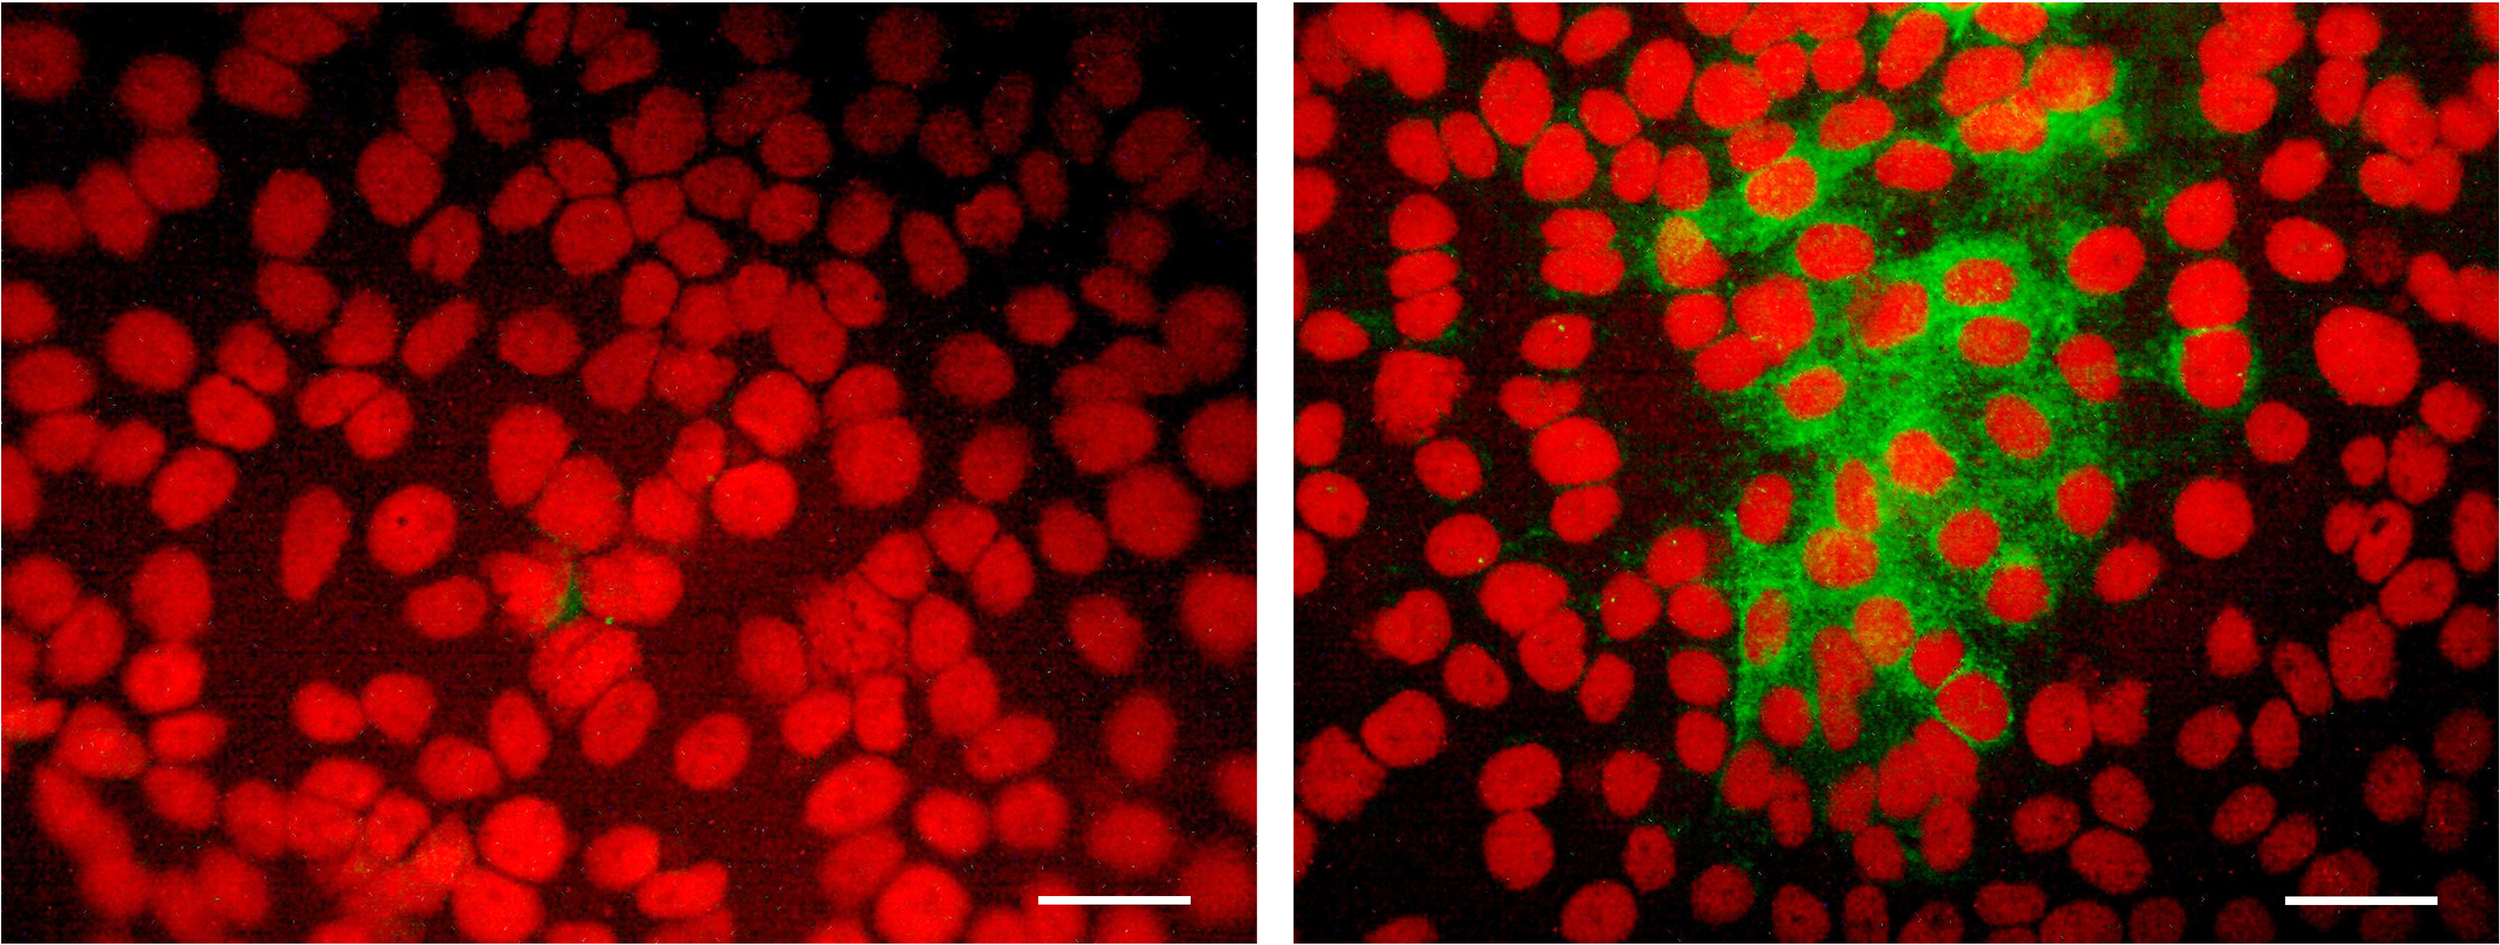

Abstract
Effective and simple delivery of DNA vaccines remains a key to successful clinical applications. Previously, we developed a novel class of DNA vaccines, sometimes called iDNA, which encodes the whole live-attenuated vaccine viruses. Compared to a standard DNA vaccine, an iDNA vaccine required a low dose to launch a live-attenuated vaccine in vitro or in vivo. The goal of this pilot study was to investigate if iDNA vaccine encoding live-attenuated Venezuelan equine encephalitis virus (VEEV) can be efficiently delivered in vivo by a microneedle device using a single-dose vaccination with naked iDNA plasmid. For this purpose, we used pMG4020 plasmid encoding live-attenuated V4020 vaccine of VEE virus. The V4020 virus contains structural gene rearrangement, as well as attenuating mutations genetically engineered to prevent reversion mutations. The pMG4020 was administered to experimental rabbits by using a hollow microstructured transdermal system (hMTS) microneedle device. No adverse events to vaccination were noted. Animals that received pMG4020 plasmid have successfully seroconverted, with high plaque reduction neutralization test (PRNT) antibody titers, similar to those observed in animals that received V4020 virus in place of the pMG4020 iDNA plasmid. We conclude that naked iDNA vaccine can be successfully delivered in vivo by using a single-dose vaccination with a microneedle device.
Introduction
Venezuelan equine encephalitis virus (VEEV) is a mosquito-borne alphavirus (Togaviridae family), which causes human disease outbreaks and equine epizootics, mostly in the South, Central, and North America (1, 2). Climate, ecological changes, and international travel increase the risk of VEEV reemergence (3–5). In addition, VEEV is a potential bioterrorism threat (3). Currently, there is no licensed human vaccine for VEEV, and the potential risks of VEEV outbreaks necessitate the development of a safe and effective vaccine (6).
DNA-based vaccines have great potential as a vaccination strategy due to the simplicity of production, genetic and chemical stability, and no requirement for a cold chain. We recently developed an iDNA approach to launch live-attenuated vaccines from DNA plasmids. Live-attenuated vaccines have the advantage of rapidly inducing natural, long-lasting, protective immunity, which makes them the ideal vaccines to contain outbreaks. However, because of the high rates of mutation in RNA viruses (7, 8), there is a concern that live vaccines consist of a heterologous population and can potentially acquire reversion mutations in the process of multiple passages during vaccine production, leading to regeneration of the wild-type, virulent phenotype. For example, safety considerations have hindered Food and Drug Administration (FDA) approval of TC83, a live-attenuated VEEV vaccine developed in the 1960s (9, 10). The TC83 vaccine includes two attenuating mutations, 5′A3 and E2-Arg120. Genetic reversions have been associated with the risk of adverse reactions (11). In contrast to a standard virus vaccine representing a population of viruses, an inherently stable iDNA plasmid represents a genetically defined vaccine, which may provide a safety advantage.
In addition, V4020 VEEV iDNA vaccine was engineered for improved safety, including additional attenuation strategies for preventing reversion mutations (12). The V4020 vaccine was prepared using an iDNA infectious clone that encodes the full-length rearranged genomic RNA downstream from the optimized CMV promoter. A recombinant plasmid pMG4020 encoding the genomic RNA of the V4020 vaccine virus has been confirmed to launch replication of a live-attenuated V4020 vaccine virus in vitro and in vivo (12, 13). Safety, immunogenicity, and protection of V4020 virus against VEEV challenges were confirmed in BALB/c mice and non-human primates (12, 14). A small dose of iDNA can be used to launch a live-attenuated virus. However, in order to launch V4020 virus in vivo, iDNA was previously delivered either using a transfection reagent or by electroporation, similarly to traditional DNA vaccines (12, 13).
In this study, we report that naked iDNA plasmid can be efficiently delivered in vivo using a simple, single-dose vaccination using a hollow microstructured transdermal system (hMTS) microneedle technology.
Materials and Methods
Cell Line, Plasmid, and Virus
The pMG4020 plasmid was described elsewhere (12). Briefly, pMG4020 encoded the full-length, rearranged RNA genome of the V4020 vaccine virus (Figure 1). The pMG4020 plasmid was grown in Escherichia coli in the presence of kanamycin and isolated using an endotoxin-free DNA isolation method (Qiagen, Valencia, CA, USA).
Figure 1

Genetic structure of the pMG4020 plasmid and V4020 VEEV vaccine virus with rearranged genome. (A) RNA genome map of V4020 virus. Indicated are 5′ cap, major open reading frames (nsP1-4, GP, C), 26S subgenomic promoters (open arrows), and 3′-Poly (A). Asterisks indicate attenuating mutations. Map is not to scale. (B) hollow microstructured transdermal system (hMTS) transdermal hollow microneedle device. Shown are vaccine injector, vaccine cartridges, microneedle array, and enlarged hollow microneedle structure. The array contains 12 microneedles; each microneedle is 1,500 μm in length. For vaccination of rabbits, vaccine cartridges were aseptically pre-loaded with 20 μg of pMG4020 or 104 PFU of V4020 live-attenuated virus. Cartridges were installed into vaccine injector, and vaccine was delivered transdermally to rabbit skin.
Vero cells (African green monkey) from the American Type Culture Collection (CCL-81.4, Manassas, VA, USA) were maintained in a humidified incubator at 37°C and 5% CO2 in αMEM supplemented with 10% fetal bovine serum (FBS) and gentamicin sulfate (10 µg/ml) (Life Technologies, Carlsbad, CA, USA).
The V4020 live-attenuated vaccine virus was prepared by transfecting Vero cells with pMG4020. Transfection was done by electroporation essentially as described elsewhere (13). Briefly, Vero cells were transfected with 1 µg of pMG4020 and incubated at 37°C. The growth medium (passage P0) was harvested at 20 h post-transfection. The V4020 P0 virus was used to infect Vero cells at a multiplicity of infection (MOI) of 0.01 to generate the V4020 passage P1 virus in 175-cm2 flasks. The P1 vaccine virus was harvested, concentrated 100-fold, partially purified by ultracentrifugation, resuspended in phosphate-buffered saline (PBS), and filter-sterilized using a 0.2-µm filter. The titer of the V4020 P1 was determined by plaque assay and adjusted with PBS to 1 × 108 PFU/ml.
Both pMG4020 plasmid and V4020 vaccine virus were confirmed for the ability to express VEEV antigens in Vero cells by immunofluorescence assay (IFA) and Western blotting. Plaque morphology was evaluated in Vero cells by plaque assay as described elsewhere (12, 13).
Microneedle Devices
Microstructured transdermal system (MTS) from 3M (Kindeva) Drug Delivery (Saint Paul, MN, USA) provides needle-free intradermal administration of small molecules and macromolecules. For vaccinations, we used a hMTS platform designed for the delivery of non-viscous liquid formulations including vaccines. The hMTS devices were a gift from 3M Corporation. These devices are prepared using medical-grade polymer and designed for fast, high-efficiency drug delivery using simple and accurate drug administration.
The cartridges for hMTS devices were aseptically filled with 0.5 ml of vaccines (either pMG4020 iDNA or V4020 virus) according to the manufacturer’s instructions. Care was taken to avoid air bubbles in the prefilled cartridges. Three hMTS devices were filled with pMG4020, while one hMTS device was filled with control V4020 live virus vaccine. The filled cartridges were crimped to properly seal the cartridge.
Immediately before vaccine application to animals, the vaccine-filled cartridges were inserted into the injector to align with the spring-powered vaccine delivery plunger mechanism. The hMTS injector contained an array of twelve preinstalled hollow microneedles to administer the vaccine to the injection site (Figure 1).
Immunizations of Rabbits
Animal research involving experimental rabbits was done according to the approved institutional protocol (Noble Life Sciences No. 493). New Zealand white rabbits were purchased from Charles River. Animals were divided into two groups, three per group. Rabbits (2.5–3 kg, adult, female) were anesthetized prior to vaccinations. One group of three animals was vaccinated using pMG4020 plasmid encoding the V4020 virus. Another group was vaccinated using the V4020 virus. Either vaccine (pMG4020 iDNA plasmid or V4020 virus) was administered using hMTS microneedle devices according to the manufacturer’s instructions. To minimize the number of animals due to ethical and animal welfare reasons, one control rabbit was injected with V4020 vaccine virus using the hMTS device, and one control rabbit was injected with V4020 vaccine virus using a standard syringe needle via subcutaneous (SC) route of administration.
The vaccine was administered on day 0. Animals were vaccinated with 0.5 ml of pMG4020 iDNA (20 μg) or V4020 virus vaccine (104 PFU) using hMTS microneedle devices or with 0.5 ml (104 PFU) of V4020 vaccine SC using a standard syringe in the right leg at a titer of 2 × 104 PFU/ml. The human dose of the TC83 vaccine is 105 PFU; therefore, 104 PFU dose was chosen for rabbits considering the difference in body weight.
The animals were placed under general anesthesia using a combination of ketamine (50 mg/kg) and xylazine (10 mg/kg), and the site of injection was cleanly shaved using clippers followed by a razor prior to application of the device and injection. The injection site skin was stretched and secured onto a solid support bar. The device was attached to the skin via a self-adhesive surface, and the injection button on the device was depressed to deliver the pre-loaded vaccine cargo from the cartridge through the microneedles. As a control, one animal was dosed SC with 0.5 ml of the attenuated VEE vaccine strain V4020 at the same amount and concentration as those in the hMTS microneedle array device.
After vaccinations, animals were observed daily. Blood samples were taken on days 0, 7, and 21. On days 0 (vaccination), 7, and 21, rabbits were bled via the auricular artery for assessment of viremia (day 7) and the humoral response (neutralizing antibodies and IFA) to the vaccines. In a previous study, viremia was detectable up to 8 days in cotton rats after SC inoculation with 3 log10 PFU of VEEV (15).
Evaluation of Viremia
After vaccination, viremia was evaluated on day 7 post-vaccination by either direct plaque assay on Vero cell Monolayers or virus amplification in Vero cells.
Briefly, 0.1 ml of serum was used for direct plaque assay. Plaques were visualized with neutral red. For virus amplification, 1 ml of serum was incubated in 75-cm2 flasks, and cell monolayers were examined daily for cytopathic effect (CPE), while cell supernatant was examined for replicating virus using plaque assay.
Evaluation of Neutralizing Antibody
Neutralizing antibodies were determined by plaque reduction neutralization tests (PRNT80 and PRNT50) in duplicate in Vero cell monolayers. For PRNT, sera were heat inactivated, and VEEV V4020 was mixed with serum dilutions before plaque assay. Dilution of serum required to cause 80% and 50% reduction of plaques was determined.
As controls, pre-bleed sera (day 0) were used to compare PRNT titers of sera from days 7 and 21 post-vaccination to PRNT titers of pre-bleed. Statistical analysis was performed using the mean logarithm of titer and Student’s t-test. Statistical analysis for potential differences between groups was not performed due to small group sizes. Cohorts of 3 animals yield adequate power to show vaccine immunogenicity (p < 0.05).
To confirm seroconversion, indirect IFA was used. Briefly, Vero cell monolayers were infected in chamber slides with V4020 virus at MOI = 0.1 for 24 h. Monolayers were fixed with cold acetone and probed with rabbit antiserum at 1:25 dilution, followed by secondary fluorescein isothiocyanate (FITC)-labeled anti-rabbit IgG (H+L) at 1:25 dilution. Monolayers were covered with a mounting medium containing propidium iodide (Vector Labs, Burlingame, CA, USA). V4020-specific rabbit serum antibodies were detected by observing fluorescent foci of V4020-infected cells.
Results
VEEV Vaccines pMG4020 and V4020
The genome of the V4020 VEEV virus with gene rearrangement and attenuating mutations is schematically shown in Figure 1. In the V4020 RNA, the capsid (C) gene was expressed using the duplicated subgenomic 26S promoter downstream from the glycoprotein (GP) genes, resulting in a gene rearrangement. V4020 also maintained both attenuating mutations 5′A3 (in the 5′ untranslated region) and E2-120Arg (in the E2 gene) derived from the TC83 sequence. However, the translational codon AGA encoding attenuating mutation E2-120Arg in the TC83 virus (16) was changed in V4020 to a synonymous codon CGA, which requires at least two mutations to revert to the wild-type VEEV E2-120Thr codon ACA (12, 14). V4020 was isolated from E. coli using the endotoxin-free method.
V4020 vaccine virus was prepared by transfecting Vero cells with pMG4020 plasmid encoding the full-length infectious RNA genome of rearranged V4020 vaccine virus (Figure 1) as described in the Materials and Methods. The titer of the resulting V4020 vaccine virus, 4 × 108 PFU/ml, was determined by standard plaque assay in Vero cell monolayers confirming synthesis of vaccine virus from the plasmid in vitro. Both iDNA plasmid and V4020 live virus vaccines were filter-sterilized before aseptically loading into hMTS devices or standard syringes.
Vaccination Using Hollow Microstructured Transdermal System Hollow Microneedle Devices
Rabbits are often used as a non-rodent animal model for the evaluation of DNA vaccines (17). Vaccination of experimental rabbits was done using hMTS hollow microneedle devices designed for the delivery of liquid formulations, representing the first application of hMTS devices in combination with iDNA (Figure 1). These devices are designed to accurately and consistently administer drugs into the dermis. The hMTS devices were preloaded with 0.5 ml of each vaccine containing either 20 μg of pMG402 iDNA plasmid or 104 PFU of live V4020 vaccine virus (control). Another control animal received a 0.5-ml dose of 104 PFU of live V4020 vaccine virus via standard SC inoculation by a syringe needle. All vaccines were formulated in PBS and sterile-filtered. After administration, the remaining vaccines were quantitated to confirm the quantity and titer of vaccines administered to experimental animals.
Immunogenicity of pMG4020 iDNA and V4020 Virus Vaccines in Rabbits
The proof-of-concept study in rabbits was performed to test the vaccine administration using hMTS microneedle devices. The hMTS devices were loaded with vaccines as described in the Materials and Methods. Rabbits were vaccinated on day 0 SC with a single dose of either 20 μg of pMG4020 or 104 PFU of V4020 vaccine virus (Figure 2 and Table 1).
Figure 2

(A) Schematic diagram of vaccination of rabbits (Oryctolagus cuniculus) with the pMG4020 or V4020 vaccine. The study timeline is shown from day −7 before vaccination through day 38 after vaccination. Vaccinations were performed on day 0 (open triangle). Blood draws are indicated with filled triangles. Rabbits were vaccinated with 20 μg of pMG4020 transdermally using hollow microstructured transdermal system (hMTS) hollow microneedle devices, or with 104 PFU V4020 live-attenuated using hMTS devices, or with 104 PFU of V4020 virus using syringe needle SC as described in the Materials and Methods. On indicated days, blood was drawn for serology. (B) Rabbit skin after vaccination with pMG4020 and hMTS microneedle device.
Table 1
| Day 0 | Day 7 | Day 21 | ||||
|---|---|---|---|---|---|---|
| Vaccine, route | Vaccine dose | PRNT50/80 | Viremia direct, PFU/ml | Viremia, by amplification, PFU/ml | PRNT80 | PRNT50 |
| 1. V4020, SC | 104 PFU | < 10 | < 10 | < 1 | < 10 | < 10 |
| 2. V4020, TD | 104 PFU | < 10 | < 10 | < 1 | 640 | 5,120 |
| 3. pMG4020, TD | 20 μg | < 10 | < 10 | < 1 | 320 | 1,280 |
| 4. pMG4020, TD | 20 μg | < 10 | < 10 | < 1 | 40 | 160 |
| 5. pMG4020, TD | 20 μg | < 10 | < 10 | < 1 | 640 | 1,280 |
Immunogenicity of pMG4020 and V4020 vaccines in rabbits.
Pre-bleed sera (day 0) were used to compare PRNT titers of sera from days 7 and 21 post-vaccination to PRNT titers of pre-bleed. Statistical analysis was performed using mean logarithm of titer (day 21) and one-sided Student’s t-test.
V4020, live-attenuated virus; pMG4020, iDNA plasmid; SC, subcutaneously using syringe; TD, transdermally using 3M (Kindeva) hMTS devices; PRNT, plaque reduction neutralization test.
All animals were closely monitored after vaccination signs of illness from either the pMG4020 or from the V4020 vaccine virus including their appearance, behavioral changes, and food and water consumption. All animals assigned to the study survived for the duration of the study. There were no apparent adverse reactions to vaccination. No abnormal behavior was noted during the entire period of observation. Serum samples collected on day 7 post-vaccination were examined for virus neutralization and viremia. Viremia was not detectable at day 7 post-vaccination either by direct plaque assay or by amplification in Vero cell monolayers, suggesting that there is no detectable viremia in rabbits on day 7 after vaccination.
On day 21, all three vaccinated rabbits in the iDNA-vaccinated group seroconverted on day 21, as shown by PRNT80 and PRNT50. The PRNT80 titers varied from 40 to 640 (Table 1). The two-sided t-test was statistically significant. One-sided t-test also showed statistical significance p < 0.05 (p = 0.012). The PRNT80 titer of 640 was also determined in animals vaccinated via hMTS microneedle devices with V4020 live vaccine. The PRNT50 titers also showed seroconversion on day 21 in either pMG4020- or V4020-vaccinated animals (Table 1). One animal in the pMG4020-vaccinated group showed slightly lower PRNT80 and PRNT50 titers, at 40 and 160, respectively. To confirm seroconversion in this animal, serum was probed by IFA using Vero cell monolayers infected with the V4020 virus at MOI 0.1. Positive fluorescent foci were detected using rabbit serum collected on day 21 but not on day 0 (Figure 3), thus confirming seroconversion, also detected by PRNT80 and PRNT50 (Table 1). Surprisingly, the animal that received a single-dose SC vaccination via standard syringe inoculation did not seroconvert, suggesting a potential technical issue (Table 1).
Figure 3
Detection of V4020-specific antibody by immunofluorescence assay (IFA) in Vero cell monolayers infected with V4020 virus at multiplicity of infection (MOI) = 0.1. Serum was collected from pMG4020-vaccinated rabbit on day 0 (left panel) and day 21 (right panel) and used as primary antibody to detect foci of V4020 virus in Vero cell monolayers. Secondary antibody was fluorescein isothiocyanate (FITC)-labeled goat anti-rabbit IgG (H+L). Mounting medium containing propidium iodide counterstain (Vector Labs, Burlingame, CA, USA) was used to visualize nuclei of the cells in red fluorescence. Positive green fluorescence indicates detection of VEEV antigen using serum antibody (day 21) from vaccinated rabbits. Bar, 50 μM.
Taken together, these results demonstrated that both pMG4020 naked DNA and V4020 virus vaccinations are safe and immunogenic via hMTS hollow microneedle devices. Additional studies are warranted to confirm this proof-of-concept observation.
Discussion
Efficient vaccination with DNA vaccines remains among the most important goals of current vaccinology (18–20). Although shown safe and effective in animal models, standard DNA vaccines demonstrate limited success in humans and sometimes require large doses, multiple booster vaccinations, advanced adjuvants, novel formulations, and/or complex delivery equipment including in vivo electroporation. It should be also noted that traditional DNA vaccines encode mRNA to express subunit vaccines. Subunit vaccines themselves often have low immunogenicity and require adjuvants for improved immunogenicity and efficacy (21).
To overcome the hurdle of effective implementation of DNA-based vaccines, in this pilot feasibility study, we combined two innovative technologies, iDNA and microneedles, to deliver DNA-based vaccines in vivo.
Firstly, we used recently developed “immunization DNA” (iDNA) that encodes the full-length genomic RNA of the live attenuated VEEV vaccine. Thus, unlike standard DNA vaccines, an iDNA encodes the whole live-attenuated virus. Only a small dose of iDNA is required to launch a live-attenuated vaccine, which then self-replicates and induces efficient immune response and protection as demonstrated in animal models (12–14, 22).
Secondly, we configured hMTS hollow microneedle platform for delivery of liquid formulations of iDNA and virus vaccines in vivo. These devices are designed for easy, comfortable self-application, eliminating standard syringe needles. The hMTS can be used for fast, high volume, efficient pain-free delivery of liquid formulations including vaccines (23). Microneedles are easy to dispose of, and there is no potential for accidental needle exposure. They are expected to generate pharmacokinetic profiles similar to SC administration with some drugs. Potentially, hMTS combine the comfort of a patch with the efficiency of a syringe and can be used to minimize transitional studies from approved formulations currently administered by other injection routes. In the previous human clinical studies, minimal discomfort was associated with the application of hMTS arrays, and the hMTS infusion was well-tolerated (24). The hMTS structures are made from medical-grade, class VI materials, and a cap protects the microneedle array. Upon removal of the cap, the patient simply adheres to the single-use delivery system to the skin of his or her thigh or abdomen and presses down to begin dosing of liquid formulations of 0.5 to 2 ml.
Here we used hMTS devices to deliver PBS-formulated iDNA vaccine for VEEV to rabbits for proof-of-concept immunogenicity study. VEEV is capable of causing explosive outbreaks and can be spread by many mosquito vectors including Culex, Mansonia, Psorophora, and Aedes species (5, 25–27). Live-attenuated vaccines are among the most cost-effective and broadly used public health measures representing approximately half of all FDA-licensed vaccines. In recent years, live vaccines Zostavax, FluMist, Rotarix, and others have been approved for human use, demonstrating that live vaccines can be configured to meet FDA safety standards (28, 29). The TC83 live-attenuated vaccine for VEEV was developed decades ago by classic virology using multiple passages in tissue culture to select attenuating mutations (9, 16). Previously, we have reported the rearranged V4020 vaccine (12). Rearranged genomes lead to attenuation in many viruses including VEEV, which are resistant to reversions because many independent mutations are required to restore the wild-type virus sequence (29–32). The V4020 vaccine includes both genomic rearrangements and genetically stabilized attenuating mutations derived from the TC83 vaccine. In a previous study in BALB/c mice, V4020 and TC83 had comparable immunogenicity and protective efficacy, while V4020 had safety advantages (12, 33). We also showed that V4020 derived from pMG4020 iDNA is immunogenic and efficacious in cynomolgus macaques against aerosol challenge with pathogenic VEEV (14). Recent examples of other promising VEEV vaccines also included standard DNA vaccines expressing VEEV antigens (34–36).
When rapid containment of outbreaks is needed, live-attenuated vaccines have advantages because they induce rapid and strong immunity with a single dose. Cost considerations are important when a large number of doses are needed for vaccination, for example, in endemic countries (37, 38). The pMG4020 iDNA is a novel way to deliver live-attenuated VEEV vaccine in vivo via DNA immunization. It has been shown that iDNA is launching live-attenuated viruses in vitro or in vivo (12, 13, 22, 39). V4020 can be either prepared in vitro or used for vaccination as a live-attenuated vaccine, or it can be synthesized in tissues in vivo using vaccination with pMG4020 plasmid encoding RNA genome of V4020. In the iDNA infectious clone technology, the full-length RNA is transcribed in the nucleus from the plasmid and transported into the cytoplasm. We also used iDNA infectious clone technology to prepare experimental vaccines for the chikungunya alphavirus (39), as well as for yellow fever and Japanese encephalitis flaviviruses (40, 41). In this study, we provide proof-of-concept feasibility data that iDNA vaccines such as the pMG4020 VEEV vaccine can be potentially delivered by a microneedle technology as naked DNA to launch the live-attenuated vaccine in vivo. Potentially, multiple types of microneedle and other delivery technologies can be utilized for efficient iDNA vaccination. More studies are planned, including the length of vaccine production from the iDNA plasmid, innate and cellular immune responses, and ELISA antibody titers and assessing chemistry of serum (BMP + AST/ALT + muscle enzymes such as CK/aldolase) to evaluate potential reactogenicity of vaccination. The DNA format has multiple advantages, such as longer shelf life in warm climates (22) and genetic stability, while the ability to launch live attenuated vaccine provides the iDNA with the ability to induce immune response and protection with a single vaccination, which can be especially important in epidemic scenarios.
Funding
Research reported in this publication was supported by the National Institute of Allergy and Infectious Diseases of the National Institutes of Health under Award Numbers AI094863, AI152717.
Publisher’s Note
All claims expressed in this article are solely those of the authors and do not necessarily represent those of their affiliated organizations, or those of the publisher, the editors and the reviewers. Any product that may be evaluated in this article, or claim that may be made by its manufacturer, is not guaranteed or endorsed by the publisher.
Statements
Data availability statement
The original contributions presented in the study are included in the article/supplementary material. Further inquiries can be directed to the corresponding author.
Ethics statement
The animal study was reviewed and approved by Noble Life Sciences.
Author contributions
PP drafted the manuscript. IT conducted experiments. MT provided critical materials. JV edited the manuscript. All authors listed have made a substantial, direct, and intellectual contribution to the work and approved it for publication.
Acknowledgments
We sincerely thank 3M Company for providing hMTS devices, Igor Lukashevich for long-standing collaboration, and Noble Life Sciences, Todd Parsley, and Srujana Cherukuri for expert help in conducting the animal study. The content is solely the responsibility of the authors and does not necessarily represent the official views of the funding agencies.
Conflict of interest
IT and PP were employed by Medigen, Inc. MT was employed by 3M Company. JV was employed by Kindeva Drug Delivery.
References
1
Smart DL Trainer DO . Serologic Evidence of Venezuelan Equine Encephalitis in Some Wild and Domestic Populations of Southern Texas. J Wildlife Dis (1975) 11:195–200. doi: 10.7589/0090-3558-11.2.195
2
Weaver SC Pfeffer M Marriott K Kang W Kinney RM . Genetic Evidence for the Origins of Venezuelan Equine Encephalitis Virus Subtype IAB Outbreaks. Am J Trop Med Hyg (1999) 60:441–8. doi: 10.4269/ajtmh.1999.60.441
3
Kitchen LW Vaughn DW . Role of U.S. Military Research Programs in the Development of U.S.-Licensed Vaccines for Naturally Occurring Infectious Diseases. Vaccine (2007) 25:7017–30. doi: 10.1016/j.vaccine.2007.07.030
4
Strauss JH Strauss EG . The Alphaviruses: Gene Expression, Replication, and Evolution. Microbiol Rev (1994) 58:491–562. doi: 10.1128/mr.58.3.491-562.1994
5
Weaver SC Ferro C Barrera R Boshell J Navarro JC . Venezuelan Equine Encephalitis. Annu Rev Entomol (2004) 49:141–74. doi: 10.1146/annurev.ento.49.061802.123422
6
Paessler S Weaver SC . Vaccines for Venezuelan Equine Encephalitis. Vaccine (2009) 27 Suppl 4:D80–5. doi: 10.1016/j.vaccine.2009.07.095
7
Coffey LL Beeharry Y Borderia AV Blanc H Vignuzzi M . Arbovirus High Fidelity Variant Loses Fitness in Mosquitoes and Mice. Proc Natl Acad Sci USA (2011) 108:16038–43. doi: 10.1073/pnas.1111650108
8
Weaver SC Bellew LA Gousset L Repik PM Scott TW Holland JJ . Diversity Within Natural Populations of Eastern Equine Encephalomyelitis Virus. Virology (1993) 195:700–9. doi: 10.1006/viro.1993.1421
9
Berge TO Banks IS Tigertt WD . Attenuation of Venezuelan Equine Encephalomyelitis Virus by In Vitro Cultivation in Guinea-Pig Heart Cells. Am J Trop Med Hyg (1961) 73:209–18. doi: 10.1093/oxfordjournals.aje.a120178
10
Pittman PR Makuch RS Mangiafico JA Cannon TL Gibbs PH Peters CJ . Long-Term Duration of Detectable Neutralizing Antibodies After Administration of Live-Attenuated VEE Vaccine and Following Booster Vaccination With Inactivated VEE Vaccine. Vaccine (1996) 14:337–43. doi: 10.1016/0264-410X(95)00168-Z
11
Kenney JL Volk SM Pandya J Wang E Liang X Weaver SC . Stability of RNA Virus Attenuation Approaches. Vaccine (2011) 29:2230–4. doi: 10.1016/j.vaccine.2011.01.055
12
Tretyakova I Tibbens A Jokinen JD Johnson DM Lukashevich IS Pushko P . Novel DNA-Launched Venezuelan Equine Encephalitis Virus Vaccine With Rearranged Genome. Vaccine (2019) 37:3317–25. doi: 10.1016/j.vaccine.2019.04.072
13
Tretyakova I Lukashevich IS Glass P Wang E Weaver S Pushko P . Novel Vaccine Against Venezuelan Equine Encephalitis Combines Advantages of DNA Immunization and a Live Attenuated Vaccine. Vaccine (2013) 31:1019–25. doi: 10.1016/j.vaccine.2012.12.050
14
Tretyakova I Plante KS Rossi SL Lawrence WS Peel JE Gudjohnsen S et al . Venezuelan Equine Encephalitis Vaccine With Rearranged Genome Resists Reversion and Protects Non-Human Primates From Viremia After Aerosol Challenge. Vaccine (2020) 38:3378–86. doi: 10.1016/j.vaccine.2020.02.007
15
Carrara AS Coffey LL Aguilar PV Moncayo AC Da Rosa AP Nunes MR et al . Venezuelan Equine Encephalitis Virus Infection of Cotton Rats. Emerg Infect Dis (2007) 13:1158–65. doi: 10.3201/eid1308.061157
16
Kinney RM Chang GJ Tsuchiya KR Sneider JM Roehrig JT Woodward TM et al . Attenuation of Venezuelan Equine Encephalitis Virus Strain TC-83 Is Encoded by the 5’-Noncoding Region and the E2 Envelope Glycoprotein. J Virol (1993) 67:1269–77. doi: 10.1128/jvi.67.3.1269-1277.1993
17
Mucker EM Karmali PP Vega J Kwilas SA Wu H Joselyn M et al . Lipid Nanoparticle Formulation Increases Efficiency of DNA-Vectored Vaccines/Immunoprophylaxis in Animals Including Transchromosomic Bovines. Sci Rep (2020) 10:8764. doi: 10.1038/s41598-020-65059-0
18
Hooper J Paolino KM Mills K Kwilas S Josleyn M Cohen M et al . A Phase 2a Randomized, Double-Blind, Dose-Optimizing Study to Evaluate the Immunogenicity and Safety of a Bivalent DNA Vaccine for Hemorrhagic Fever With Renal Syndrome Delivered by Intramuscular Electroporation. Vaccines (Basel) (2020) 8:1–20. doi: 10.3390/vaccines8030377
19
Xu Z Ho M Bordoloi D Kudchodkar S Khoshnejad M Giron L et al . Techniques for Developing and Assessing Immune Responses Induced by Synthetic DNA Vaccines for Emerging Infectious Diseases. Methods Mol Biol (2022) 2410:229–63. doi: 10.1007/978-1-0716-1884-4_11
20
Bordoloi D Xiao P Choi H Ho M Perales-Puchalt A Khoshnejad M et al . Immunotherapy of Prostate Cancer Using Novel Synthetic DNA Vaccines Targeting Multiple Tumor Antigens. Genes Cancer (2021) 12:51–64. doi: 10.18632/genesandcancer.214
21
Mekonnen D Mengist HM Jin T . SARS-Cov-2 Subunit Vaccine Adjuvants and Their Signaling Pathways. Expert Rev Vaccines (2021) 21(1):1–13. doi: 10.1080/14760584.2021.1991794
22
Pushko P Lukashevich IS Weaver SC Tretyakova I . DNA-Launched Live-Attenuated Vaccines for Biodefense Applications. Expert Rev Vaccines (2016) 15:1223–34. doi: 10.1080/14760584.2016.1175943
23
Burton SA Ng CY Simmers R Moeckly C Brandwein D Gilbert T et al . Rapid Intradermal Delivery of Liquid Formulations Using a Hollow Microstructured Array. Pharm Res (2011) 28:31–40. doi: 10.1007/s11095-010-0177-8
24
Block MS Dietz AB Gustafson MP Kalli KR Erskine CL Youssef B et al . Th17-Inducing Autologous Dendritic Cell Vaccination Promotes Antigen-Specific Cellular and Humoral Immunity in Ovarian Cancer Patients. Nat Commun (2020) 11:5173. doi: 10.1038/s41467-020-18962-z
25
Brault AC Powers AM Ortiz D Estrada-Franco JG Navarro-Lopez R Weaver SC . Venezuelan Equine Encephalitis Emergence: Enhanced Vector Infection From a Single Amino Acid Substitution in the Envelope Glycoprotein. Proc Natl Acad Sci USA (2004) 101:11344–9. doi: 10.1073/pnas.0402905101
26
Scherer WF Weaver SC Taylor CA Cupp EW Dickerman RW Rubino HH . Vector Competence of Culex (Melanoconion) Taeniopus for Allopatric and Epizootic Venezuelan Equine Encephalomyelitis Viruses. Am J Trop Med Hyg (1987) 36:194–7. doi: 10.4269/ajtmh.1987.36.194
27
Go YY Balasuriya UB Lee CK . Zoonotic Encephalitides Caused by Arboviruses: Transmission and Epidemiology of Alphaviruses and Flaviviruses. Clin Exp Vaccine Res (2014) 3:58–77. doi: 10.7774/cevr.2014.3.1.58
28
Vaughn JA Miller RA . Update on Immunizations in Adults. Am Family Physician (2011) 84:1015–20.
29
Bull JJ . Evolutionary Reversion of Live Viral Vaccines: Can Genetic Engineering Subdue It? Virus Evol (2015) 1:1–10. doi: 10.1093/ve/vev005
30
Pushko P Parker MD Smith JF Crise BJ . Live Attenuated Venezuelan Equine Encephalitis Vaccine. U.S. Patent 6296854 (2001). USPTO.
31
Flanagan EB Schoeb TR Wertz GW . Vesicular Stomatitis Viruses With Rearranged Genomes Have Altered Invasiveness and Neuropathogenesis in Mice. J Virol (2003) 77:5740–8. doi: 10.1128/JVI.77.10.5740-5748.2003
32
Rouxel RN Tafalla C Merour E Leal E Biacchesi S Bremont M . Attenuated Infectious Hematopoietic Necrosis Virus With Rearranged Gene Order as Potential Vaccine. J Virol (2016) 90:10857–66. doi: 10.1128/JVI.01024-16
33
Johnson DM Sokoloski KJ Jokinen JD Pfeffer TL Chu YK Adcock RS et al . Advanced Safety and Genetic Stability in Mice of a Novel DNA-Launched Venezuelan Equine Encephalitis Virus Vaccine With Rearranged Structural Genes. Vaccines (Basel) (2020) 8:1–19. doi: 10.3390/vaccines8010114
34
Dupuy LC Richards MJ Ellefsen B Chau L Luxembourg A Hannaman D et al . A DNA Vaccine for Venezuelan Equine Encephalitis Virus Delivered by Intramuscular Electroporation Elicits High Levels of Neutralizing Antibodies in Multiple Animal Models and Provides Protective Immunity to Mice and Nonhuman Primates. Clin Vaccine Immunol (2011) 18:707–16. doi: 10.1128/CVI.00030-11
35
Dupuy LC Richards MJ Reed DS Schmaljohn CS . Immunogenicity and Protective Efficacy of a DNA Vaccine Against Venezuelan Equine Encephalitis Virus Aerosol Challenge in Nonhuman Primates. Vaccine (2010) 28:7345–50. doi: 10.1016/j.vaccine.2010.09.005
36
Hannaman D Dupuy LC Ellefsen B Schmaljohn CS . A Phase 1 Clinical Trial of a DNA Vaccine for Venezuelan Equine Encephalitis Delivered by Intramuscular or Intradermal Electroporation. Vaccine (2016) 34:3607–12. doi: 10.1016/j.vaccine.2016.04.077
37
Wilder-Smith A Gubler DJ Weaver SC Monath TP Heymann DL Scott TW . Epidemic Arboviral Diseases: Priorities for Research and Public Health. Lancet Infect Dis (2017) 17:e101–e6. doi: 10.1016/S1473-3099(16)30518-7
38
Preiss S Garcon N Cunningham AL Strugnell R Friedland LR . Vaccine Provision: Delivering Sustained & Widespread Use. Vaccine (2016) 34:6665–71. doi: 10.1016/j.vaccine.2016.10.079
39
Tretyakova I Hearn J Wang E Weaver S Pushko P . DNA Vaccine Initiates Replication of Live Attenuated Chikungunya Virus In Vitro and Elicits Protective Immune Response in Mice. J Infect Dis (2014) 209:1882–90. doi: 10.1093/infdis/jiu114
40
Tretyakova I Nickols B Hidajat R Jokinen J Lukashevich IS Pushko P . Plasmid DNA Initiates Replication of Yellow Fever Vaccine In Vitro and Elicits Virus-Specific Immune Response in Mice. Virology (2014) 468-470:28–35. doi: 10.1016/j.virol.2014.07.050
41
Nickols B Tretyakova I Tibbens A Klyushnenkova E Pushko P . Plasmid DNA Launches Live-Attenuated Japanese Encephalitis Virus and Elicits Virus-Neutralizing Antibodies in BALB/C Mice. Virology (2017) 512:66–73. doi: 10.1016/j.virol.2017.09.005
Summary
Keywords
DNA vaccine, live-attenuated vaccine, iDNA, Venezuelan equine encephalitis virus, VEE, TC83, V4020, microneedle
Citation
Tretyakova I, Tomai M, Vasilakos J and Pushko P (2022) Live-Attenuated VEEV Vaccine Delivered by iDNA Using Microneedles Is Immunogenic in Rabbits. Front. Trop. Dis 3:813671. doi: 10.3389/fitd.2022.813671
Received
12 November 2021
Accepted
10 February 2022
Published
18 March 2022
Volume
3 - 2022
Edited by
Kar Muthumani, GeneOne Life Science, Inc., South Korea
Reviewed by
Ziyang Xu, University of Pennsylvania, United States; Neethu Chokkalingam, Wistar Institute, United States
Updates
Copyright
© 2022 Tretyakova, Tomai, Vasilakos and Pushko.
This is an open-access article distributed under the terms of the Creative Commons Attribution License (CC BY). The use, distribution or reproduction in other forums is permitted, provided the original author(s) and the copyright owner(s) are credited and that the original publication in this journal is cited, in accordance with accepted academic practice. No use, distribution or reproduction is permitted which does not comply with these terms.
*Correspondence: Peter Pushko, ppushko@medigen-usa.com
This article was submitted to Vaccines for Tropical Diseases, a section of the journal Frontiers in Tropical Diseases
Disclaimer
All claims expressed in this article are solely those of the authors and do not necessarily represent those of their affiliated organizations, or those of the publisher, the editors and the reviewers. Any product that may be evaluated in this article or claim that may be made by its manufacturer is not guaranteed or endorsed by the publisher.